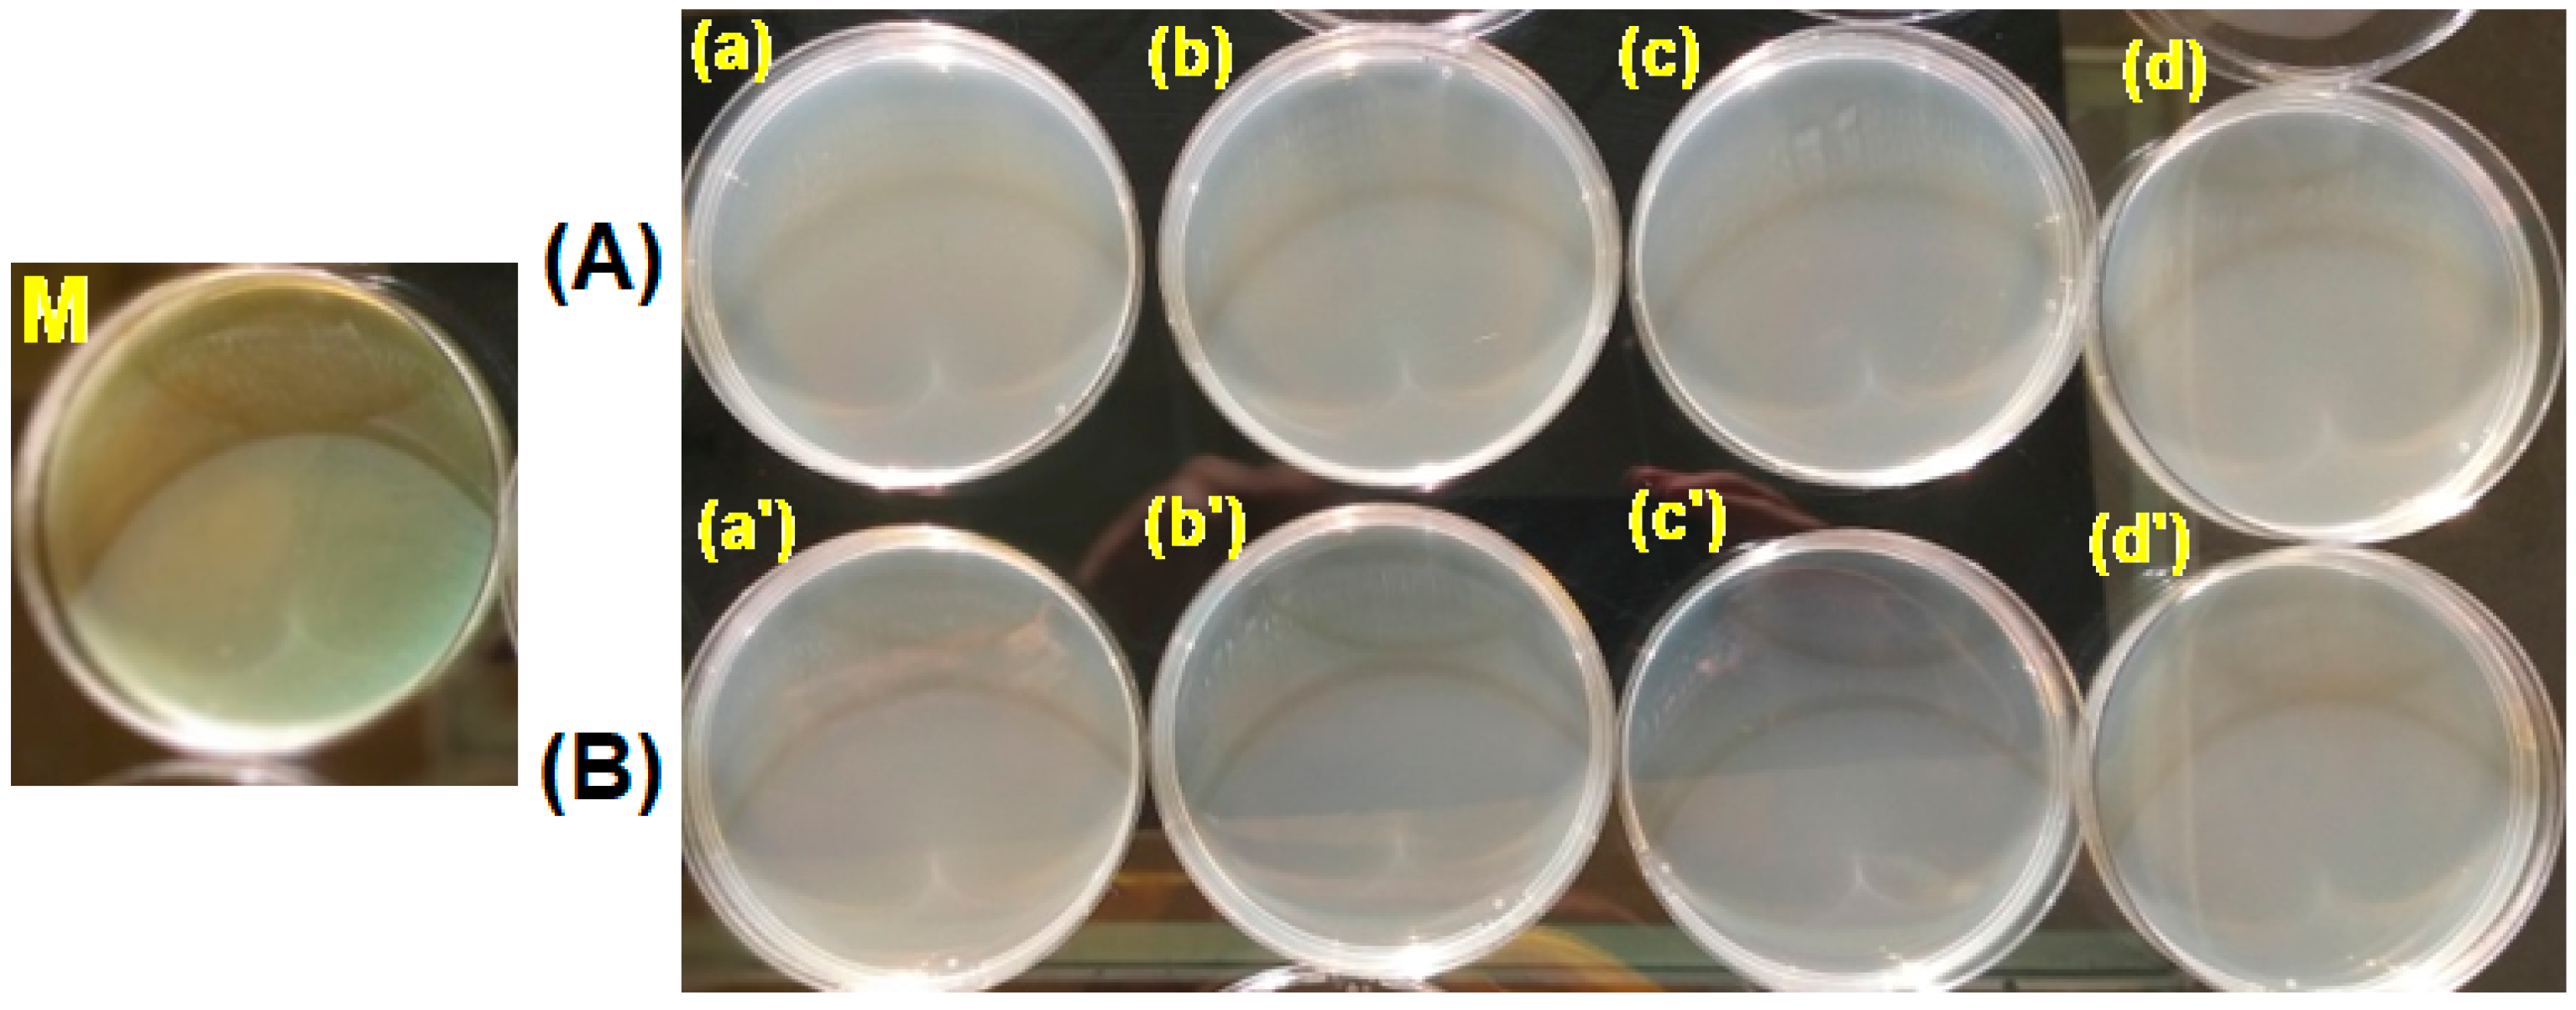
Polymers 15 00877 g014

Structure-Bioactivity Relationship of the Functionalized Polysulfone with Triethylphosphonium Pendant Groups: Perspective for Biomedical Applications
Abstract
:1. Introduction
2. Materials and Methods
3. Results and Discussion
3.1. Synthesis and Characterization of Functionalized Polysulfone with Triethylphosphonium Pendant Groups
3.2. Conformational Characteristics of Functionalized Polysulfone with Triethylphosphonium Pendant Groups Evaluated by Rheological Parameters
3.2.1. Dynamic Viscosity
3.2.2. Oscillatory Shear Parameters
3.3. Testing the Antimicrobial Capacity
4. Conclusions
Supplementary Materials
Author Contributions
Funding
Institutional Review Board Statement
Informed Consent Statement
Data Availability Statement
Conflicts of Interest
References
- Wang, Y.; Xu, H.; Zhang, J.; Li, G. Electrochemical sensors for clinic analysis. Sensors 2008, 8, 2043–2081. [Google Scholar] [CrossRef] [PubMed]
- Sánchez, S.; Pumera, M.; Fàbregas, E. Carbon nanotube/polysulfone screen-printed electrochemical immunosensor. Biosens. Bioelectron. 2007, 23, 332–340. [Google Scholar] [CrossRef] [PubMed]
- Sánchez, S.; Pumera, M.; Cabruja, E.; Fàbregas, E. Carbon nanotube/polysulfone composite screen-printed electrochemical enzyme biosensors. Analyst 2007, 132, 142–147. [Google Scholar] [CrossRef] [PubMed]
- Baranwal, J.; Barse, B.; Gatto, G.; Broncova, G.; Kumar, A. Electrochemical sensors and their applications: A review. Chemosensors 2022, 10, 363. [Google Scholar] [CrossRef]
- Ranjan, P.; Khan, R. Electrochemical immunosensor for early detection of β-amyloid alzheimer’s disease biomarker based on aligned carbon nanotubes gold nanocomposites. Biosensors 2022, 12, 1059. [Google Scholar] [CrossRef]
- Ricci, F.; Volpe, G.; Micheli, L.; Palleschi, G. A review on novel developments and applications of immunosensors in food analysis. Anal. Chim. Acta 2007, 605, 111–129. [Google Scholar] [CrossRef]
- Deng, H.T.; Xu, Z.K.; Liu, Z.M.; Wu, J.; Ye, P. Adsorption immobilization of Candida rugosa lipases on polypropylene hollow fiber microfiltration membranes modified by hydrophobic polypeptides. Enzyme Microb. Technol. 2004, 35, 437–443. [Google Scholar] [CrossRef]
- Knežević, Z.; Milosavić, N.; Bezbradica, D.; Jakovljević, Z.; Prodanović, R. Immobilization of lipase from Candida rugosa on Eupergit®C supports by covalent attachment. Biochem. Eng. J. 2006, 30, 269–278. [Google Scholar] [CrossRef]
- Palomo, J.M.; Segura, R.L.; Fernández-Lorente, G.; Pernas, M.; Rua, M.L.; Guisán, J.M.; Fernández-Lafuente, R. Purification, immobilization, and stabilization of a lipase from Bacillus thermocatenulatus by interfacial adsorption on hydrophobic supports. Biotechnol. Progr. 2004, 20, 630–635. [Google Scholar] [CrossRef]
- Gupta, S.; Yogesh, S.J.; Bhambi, M.; Pundir, C.S.; Singh, K.; Bhattacharya, A. Comparative study of performances of lipase immobilized asymmetric polysulfone and polyether sulfone membranes in olive oil hydrolysis. Int. J. Biol. Macromol. 2008, 42, 145–151. [Google Scholar] [CrossRef]
- Appavoo, D.; Park, S.-Y.; Zhai, L. Responsive polymers for medical diagnostics. J. Mat. Chem. B 2020, 8, 6217–6232. [Google Scholar] [CrossRef] [PubMed]
- Ngoepe, M.; Choonara, Y.E.; Tygai, C.; Tomar, L.K.; du Toit, L.C.; Kumar, P.; Ndesendo, V.M.K.; Pillay, V. Integration of biosensors and drug delivery technologies for early detection and chronic management of illness. Sensors 2013, 13, 7680–7713. [Google Scholar] [CrossRef] [PubMed]
- Ren, K.; Zhou, J.; Wu, H. Materials for microfluidic chip fabrication. Acc. Chem. Res. 2013, 46, 2396–2406. [Google Scholar] [CrossRef] [PubMed]
- Hu, J.; Liu, S. Responsive polymers for detection and sensing applications: Current status and future developments. Macromolecules 2010, 43, 8315–8330. [Google Scholar] [CrossRef]
- Nie, S.; Xue, J.; Lu, Y.; Liu, Y.; Wang, D.; Sun, S.; Ran, F.; Zhao, C. Improved blood compatibility of polyethersulfone membrane with a hydrophilic and anionic surface. Colloid Surf. B Biointerfaces 2012, 100, 116–125. [Google Scholar] [CrossRef]
- Barzin, J.; Madaeni, S.S.; Mirzadeh, H.; Mehrabzadeh, M. Effect of polyvinylpyrrolidone on morphology and performance of hemodialysis membranes prepared from polyether sulfone. J. Appl. Polym. Sci. 2004, 92, 3804–3813. [Google Scholar] [CrossRef]
- Edward, V.A.; Pillay, V.L.; Swart, P.; Singh, S. Localisation of thermomyces lanuginosus SSBP xylanase on polysulphone membranes using immunogold labelling and environmental scanning electron microscopy (ESEM). Process Biochem. 2003, 38, 939–943. [Google Scholar] [CrossRef]
- Sanchez, S.; Fàbregas, E. New antibodies immobilization system into a graphite-polysulfone membrane for amperometric immunosensors. Biosens. Bioelectron. 2007, 22, 965–972. [Google Scholar] [CrossRef]
- Ahmad, A.; Tariq, S.; Zaman, J.U.; Perales, A.I.M.; Mubashir, M.; Luque, R. Recent trends and challenges with the synthesis of membranes: Industrial opportunities towards environmental remediation. Chemosphere 2022, 306, 135634. [Google Scholar] [CrossRef]
- Wu, H.; Shi, C.; Zhu, Q.; Li, Y.; Xu, Z.; Wei, C.; Chen, D.; Huang, X. Capillary-driven blood separation and in-situ electrochemical detection based on 3D conductive gradient hollow fiber membrane. Biosens. Bioelectron. 2021, 171, 112722. [Google Scholar] [CrossRef]
- Kanazawa, A.; Ikeda, T.; Endo, T. A novel approach to mode of action of cationic biocides morphological effect on antibacterial activity. J. Polym. Sci. A Polym. Chem. 1993, 31, 1467–1472. [Google Scholar] [CrossRef]
- Frackowiak, E.; Lota, G.; Pernak, J. Room-temperature phosphonium ionic liquids for supercapacitor application. J. Appl. Phys. Lett. 2005, 86, 164104. [Google Scholar] [CrossRef]
- Bradaric, C.J.; Downard, A.; Kennedy, C.; Robertson, A.J.; Zhou, Y. Industrial preparation of phosphonium ionic liquids. Green Chem. 2003, 5, 143–152. [Google Scholar] [CrossRef]
- Filimon, A.; Avram, E.; Dunca, S. Surface and interface properties of functionalized polysulfones: Cell-material interaction and antimicrobial activity. Polym. Eng. Sci. 2015, 55, 2184–2194. [Google Scholar] [CrossRef]
- Filimon, A.; Stoica, I.; Onofrei, M.D.; Bargan, A.; Dunca, S. Quaternized polysulfones-based blends: Surface properties and performance in life quality and environmental applications. Polym. Test. 2018, 71, 285–295. [Google Scholar] [CrossRef]
- Xie, W.; Xie, R.; Pan, W.; Hunter, D.; Koene, B.; Tan, L.; Vaia, R. Thermal stability of quaternary phosphonium modified montmorillonites. Chem. Mater. 2002, 14, 4837–4845. [Google Scholar] [CrossRef]
- Parent, J.S.; Penciu, A.; Guillen-Castellanos, S.A.; Liskova, A.; Whitney, R.A. Synthesis and characterization of isobutylene-based ammonium and phosphonium bromide ionomers. Macromolecules 2004, 37, 7477–7483. [Google Scholar] [CrossRef]
- Eisenberg, A.; Hird, B.; Moore, R.B. A new multiplet-cluster model for the morphology of random ionomers. Macromolecules 1990, 23, 4098–4107. [Google Scholar] [CrossRef]
- Unal, S. Synthesis and Characterization of Branched Macromolecules for High Performance Elastomers, Fibers, and Films. Ph.D. Thesis, Virginia Polytechnic and State University, Blacksburg, VA, USA, 2005. [Google Scholar]
- Popa, A.; Davidescu, C.M.; Trif, R.; Ilia, G.; Iliescu, S.; Dehelean, G. Study of quaternary ‘onium’ salts grafted on polymers: Antibacterial activity of quaternary phosphonium salts grafted on ‘gel-type’ styrenedivinylbenzene copolymers. React. Funct. Polym. 2003, 55, 151–158. [Google Scholar] [CrossRef]
- Koga, Y.; Meguro, H.; Fujieda, H.; Ueno, Y.; Miwa, K.; Kainoh, M. A new hydrophilic polysulfone hemodialysis membrane can prevent platelet–neutrophil interactions and successive neutrophil activation. Int. J. Artif. Organs 2019, 42, 175–181. [Google Scholar] [CrossRef] [Green Version]
- Chen, Y.; Lin, B.; Qiu, Y. Modification of polysulfone and the biomedical application of modified polysulfone. Int. J. Polym. Mat. Polym. Biomat. 2023, 72, 224–242. [Google Scholar] [CrossRef]
- Avram, E.; Butuc, E.; Luca, C.; Druta, I. Polymers with pendent functional groups. III. Polysulfone containing viologen group. J. Macromol. Sci. Part. A—Pure Appl. Chem. 1997, 34, 1701–1714. [Google Scholar] [CrossRef]
- Popa, A.; Ilia, G.; Davidescu, C.M.; Iliescu, S.; Plesu, N.; Pascariu, A.; Zhang, Z. Wittig–Hornerreactions on styrene–divinylbenzene supports with benzaldehyde side-groups. Polym. Bull. 2006, 57, 189–197. [Google Scholar] [CrossRef]
- ISO/TS 16782:2016; Clinical Laboratory Testing—Criteria for Acceptable Lots of Dehydrated Mueller-Hinton Agar and Broth for Antimicrobial Susceptibility Testing. International Organization for Standardization: Geneva, Switzerland, 2016.
- Thieme, L.; Hartung, A.; Tramm, K.; Graf, J.; Spott, R.; Makarewicz, O.; Pletz, M.W. Adaptation of the start-growth-time method for high-throughput biofilm quantification. Front. Microbiol. 2021, 12, 631248. [Google Scholar] [CrossRef] [PubMed]
- Sivaraman, K.M.; Kellenberger, C.; Pane, S.; Ergeneman, O.; Luehmann, T.; Luechinger, N.A. Porous polysulfone coatings for enhanced drug delivery. Biomed. Microdevices 2012, 14, 603–612. [Google Scholar] [CrossRef] [PubMed]
- Claes, L. Carbon fiber reinforced polysulfone--a new implant material. Biomed. Tech. 1989, 34, 315–319. [Google Scholar] [CrossRef] [PubMed]
- Von Kraemer, S.; Puchner, M.; Annasch, P.; Undblad, A.; Indbergh, G. Gas diffusion electrodes and membrane electrode assemblies based on a sulfonated polysulfone for high-temperature PEMFC. J. Electrochem. Soc. 2006, 153, A2077–A2084. [Google Scholar] [CrossRef]
- Ohya, H.; Shiki, S.; Kawakami, H. Fabrication study of polysulfone hollow-fiber microfiltration membranes: Optimal dope viscosity for nucleation and growth. J. Membr. Sci. 2009, 326, 293–302. [Google Scholar] [CrossRef]
- Nady, N.; Franssen, M.C.R.; Zuilhof, H.; Eldin, M.S.M.; Boom, R.; Schroen, K. Modification methods for poly(arylsulfone) membranes: A mini-review focusing on surface modification. Desalination 2011, 275, 1–9. [Google Scholar] [CrossRef]
- Kuroiwa, T.; Miyagishi, T.; Ito, A.; Matsuguchi, M.; Sadaoka, Y.; Sakai, Y.A. A thin-film polysulfone-based capacitive-type relative-humidity sensor. Sens. Actuat. B Chem. 1995, 25, 692–695. [Google Scholar] [CrossRef]
- Dizman, C.; Tasdelen, M.A.; Yagci, Y. Recent advances in the preparation of functionalized polysulfones. Polym. Int. 2013, 62, 991–1007. [Google Scholar] [CrossRef]
- Carbone, A.; Pedicini, R.; Gatto, I.; Saccà, A.; Patti, A.; Bella, G.; Cordaro, M. Development of polymeric membranes based on quaternized polysulfones for AMFC applications. Polymers 2020, 12, 283. [Google Scholar] [CrossRef] [PubMed]
- Serbanescu, O.S.; Voicu, S.I.; Thakur, V.K. Polysulfone functionalized membranes: Properties and challenges. Mat. Today Chem. 2020, 17, 100302. [Google Scholar] [CrossRef]
- Filimon, A.; Olaru, N.; Doroftei, F.; Coroaba, A.; Dunca, S. Processing of quaternized polysulfones solutions as tool in design of electrospun nanofibers: Microstructural characteristics and antimicrobial activity. J. Mol. Liq. 2021, 330, 115664. [Google Scholar] [CrossRef]
- Paddison, S.J.; Kreuer, K.D.; Maier, J. About the choice of the protogenic group in polymer electrolyte membranes: Ab initio modelling of sulfonic acid, phosphonic acid, and imidazole functionalized alkanes. Phys. Chem. Chem. Phys. 2006, 8, 4530–4542. [Google Scholar] [CrossRef] [PubMed]
- Reuben, H.; Adhikari, R.Y.; Tuominen, M.T.; Hanzu, I.; Wilkening, M.; Thayumanavan, S.; Katz, J.L. Evaluation of carboxylic, phosphonic and sulfonic acid protogenic moieties on tunable poly(meta-phenylene oxide) ionomer scaffolds. J. Polym. Sci. Part A Polym. Chem. 2019, 57, 2209–2213. [Google Scholar] [CrossRef]
- Quemada, D. Rheological modeling of complex fluids: IV. Thixotropic and thixoelastic behavior. Start-up and stress relaxation, creep tests and hysteresis cycles. Eur. Phys. J. Appl. Phys. 1999, 5, 191–207. [Google Scholar] [CrossRef]
- Coussot, P.; Ancey, C. Rheophysical classification of concentrated suspensions and granular pastes. Phys. Rev. E 1999, 59, 4445–4457. [Google Scholar] [CrossRef]
- Alexandrou, N.A.; Constantinoua, N.; Georgiou, G. Shear rejuvenation, aging and shear banding in yield stress fluids. J. Non-Newton. Fluid Mech. 2009, 158, 6–17. [Google Scholar] [CrossRef]
- Coussota, P.; Nguyen, Q.D.; Huynh, H.T.; Bonn, D. Viscosity bifurcation in thixotropic, yielding fluids. J. Rheol. 2002, 46, 573–589. [Google Scholar] [CrossRef] [Green Version]
- Xu, H.S.; Li, Z.M.; Yang, S.Y.; Pan, J.L.; Yang, W.; Yang, M.B. Rheological behavior comparison between PET/HDPE and PC/HDPE microfibrillar blends. Polym. Eng. Sci. 2005, 45, 1231–1238. [Google Scholar] [CrossRef]
- Watanabe, H. Viscoelasticity and dynamics of entangled polymers. Prog. Polym. Sci. 1999, 24, 1253–1403. [Google Scholar] [CrossRef]
- Chhabra, R.P. Non-Newtonian fluids: An introduction. In Rheology of Complex Fluids; Krishnan, J.M., Deshpande, A.P., Sunil Kumar, P.B., Eds.; Springer: New York, NY, USA, 2010; Chapter 1; pp. 3–34. [Google Scholar]
- Tropea, C.; Yarin, A.L.; Foss, J.F. Springer Handbook of Experimental Fluid Mechanics; Springer: Berlin/Heidelberg, Germany, 2007. [Google Scholar]
- Vazquez, M.; Schmalzing, D.; Matsudaira, P.; Ehrlich, D.; McKinley, G. Shear-induced degradation of linear polyacrylamide solutions during pre-electrophoretic loading. Anal Chem. 2001, 73, 3035–3044. [Google Scholar] [CrossRef] [PubMed]
- de Vasconcelos, C.L.; Martins, R.R.; Ferreira, M.O.; Pereira, M.R.; Fonseca, J.L.C. Rheology of polyurethane solutions with different solvents. Polym. Int. 2001, 51, 69–74. [Google Scholar] [CrossRef]
- Gupta, K.; Yaseen, M. Viscosity-temperature relationship of dilute solution of poly(vinyl chloride) in cyclohexanone and in its blends with xylene. J. Appl. Polym. Sci. 1997, 65, 2749–2760. [Google Scholar] [CrossRef]
- Ioan, S.; Buruiana, L.-I.; Petreus, O.; Avram, E.; Stoica, I.; Ioanid, G.E. Rheological and morphological properties of phosphorus-containing polysulfones. Polym. Plast. Technol. Eng. 2011, 50, 36–46. [Google Scholar] [CrossRef]
- Iiyina, E.; Daragan, V. Self-diffusion of dimethyl sulfoxide and dimethylformamide in solutions and gels of cellulose acetates by pulsed field gradient NMR. Macromolecules 1994, 27, 3759–3763. [Google Scholar] [CrossRef]
- Itagaki, H.; Tokai, M. Physical gelation process for cellulose whose hydroxyl groups are regioselectively substituted by fluorescent groups. Polymer 1997, 38, 4201–4205. [Google Scholar] [CrossRef]
- Filimon, A.; Avram, E.; Stoica, I. Rheological and morphological characteristics of multicomponent polysulfone/poly (vinyl alcohol) systems. Polym. Int. 2014, 63, 1856–1868. [Google Scholar] [CrossRef]
- Rubinstein, M.; Dobrynin, A.V. Associations leading to formation of reversible networks and gels. Curr. Opin. Colloid Interface Sci. 1999, 4, 83–87. [Google Scholar] [CrossRef]
- Xu, X.; Xu, J.; Zhang, Y.; Zhang, L. Rheology of triple helical lentinan in solution: Steady shear viscosity and dynamic oscillatory behavior. Food Hydrocoll. 2008, 22, 735–741. [Google Scholar] [CrossRef]
- Steffe, J.F. Rheological Methods in Food Process Engineering, 2nd ed.; Freeman Press: East Lansing, MI, USA, 1996. [Google Scholar]
- Chenite, A.; Buschmann, M.; Wang, D.; Chaput, C.; Kandani, N. Rheological characterisation of thermogelling chitosan/glycerol-phosphate solutions. Carbohydr. Polym. 2001, 46, 39–47. [Google Scholar] [CrossRef]
- Wolfgang, F.; Monika, S. Effects of processing conditions on the rheological behavior of collagen dispersions. Eur. J. Pharm. Biopharm. 2001, 51, 259–265. [Google Scholar] [CrossRef]
- Zhang, Y.; Xu, X.; Xu, J.; Zhang, L. Dynamic viscoelastic behavior of triple helical Lentinan in water: Effects of concentration and molecular weight. Polymer 2007, 48, 6681–6690. [Google Scholar] [CrossRef]
- Ben Ammar, N.E.; Saied, T.; Barbouche, M.; Hosni, F.; Hamzaoui, A.H.; Şen, M. A comparative study between three different methods of hydrogel network characterization: Effect of composition on the crosslinking properties using sol–gel, rheological and mechanical analyses. Polym. Bull. 2018, 75, 3825–3841. [Google Scholar] [CrossRef]
- Netti, P.A. Biomedical Foams for Tissue Engineering Applications; Elsevier: Amsterdam, The Netherlands, 2014. [Google Scholar]
- Herrera, M.L.; Hartel, R.W. Effect of processing conditions on the physical properties of milk fat model system: Rheology. J. Am. Oil. Chem. Soc. 2000, 77, 1177–1187. [Google Scholar] [CrossRef]
- Gabriele, D.; D’Antona, P.; de Cindio, B. A weak gel model for foods. Rheol. Acta 2001, 40, 120–127. [Google Scholar] [CrossRef]
- Ng, T.S.K.; McKinley, G.H. Power law gels at finite strains: The nonlinear rheology of gluten gels. J. Rheol. 2008, 52, 417–449. [Google Scholar] [CrossRef]
- Demeter, M.; Meltzer, V.; Călina, I.; Scărișoreanu, A.; Micutz, M.; Albu Kaya, M.G. Highly elastic superabsorbent collagen/PVP/PAA/PEO hydrogels crosslinked via e-beam radiation. Radiat. Phys. Chem. 2020, 174, 1088982. [Google Scholar] [CrossRef]
- Muñoz-Bonilla, A.; Cerrada, M.; Fernández-García, M. Polymeric Materials with Antimicrobial Activity: From Synthesis to Applications; Royal Society of Chemistry: Cambridge, UK, 2013. [Google Scholar]
- Muñoz-Bonilla, A.; Fernández-García, M. Polymeric materials with antimicrobial activity. Prog. Polym. Sci. 2012, 37, 281–339. [Google Scholar] [CrossRef]
- Kenawy, E.R.; Abdel-Hay, F.I.; El-Shanshoury, A.E.R.R.; El-Newehy, M.H. Biologically active polymers. V. Synthesis and antimicrobial activity of modified poly(glycidyl methacrylate-co-2-hydroxyethyl methacrylate) derivatives with quaternary ammonium and phosphonium salts. J. Polym. Sci. Part A Polym. Chem. 2002, 40, 2384. [Google Scholar] [CrossRef]
- Ong, Y.-L.; Razatos, A.; Georgiou, G.; Sharma, M.M. Adhesion forces between E. coli bacteria and biomaterial surfaces. Langmuir 1999, 15, 2719–2725. [Google Scholar] [CrossRef]
- Pacheco, A.G.; Alcântara, A.F.C.; Abreu, V.G.C.; Corrêa, G.M. Relationships between chemical structure and activity of triterpenes against Gram-positive and Gram-negative bacteria. In A Search for Antibacterial Agents; Bobbarala, V., Ed.; InTech: Rijeka, Croatia, 2012; Chapter 1; pp. 1–25. [Google Scholar]
- Berkovich, A.; Orlov, V.; Melik-Nubarov, N. Interaction of polyanions with electroneutral liposomes in a slightly acidic medium. Polym. Sci. Seria A 2009, 5, 648–657. [Google Scholar] [CrossRef]

| Properties | Sample | |
|---|---|---|
| CMPSF | PSFEtP+ | |
| (g/mol) | 29,000 | 28,000 |
| Cl (%) | 8.68 | 5.85 |
| Cli (%) | - | 4.23 |
| P (%) | - | 3.11 |
| DS (%) | 98 | 72 |
| FD (mmol/g) | - | 1.001 |
| Stage of Thermal Degradation | Ti (°C) | Tpeak (°C) | Tf (°C) | Weigh Loss (%) | Weight Loss after Decomposition (%) |
|---|---|---|---|---|---|
| I | 40 | 58 | 160 | 4.04 | 64.66 |
| II | 160 | 343 | 420 | 28.80 | |
| III | 420 | 505 | 740 | 31.82 | |
| 465 * |
| Concentration (g/mL) | A | z | Regression |
|---|---|---|---|
| 5.0 | 2.38 | 2.44 | 0.984 |
| 8.0 | 2.71 | 2.94 | 0.984 |
| 10.0 | 2.86 | 3.13 | 0.969 |
| 12.0 | 2.91 | 3.23 | 0.975 |
| Bacterial Strains | Time | C1 = 5.01 g/mL | C2 = 8.02 g/mL | C3 = 10.06 g/mL | C4 = 12.43 g/mL |
|---|---|---|---|---|---|
| (h) | (CFU/mL) | (CFU/mL) | (CFU/mL) | (CFU/mL) | |
| S. aureus | Control sample | 1.5 × 108 | 1.5 × 108 | 1.5 × 108 | 1.5 × 108 |
| T1 (3 h) | ≈1.5 × 108 | ≈1.5 × 108 | ≈1.5 × 108 | ≈1.5 × 108 | |
| T2 (24 h) | 0 × 100 | 0 × 100 | 0 × 100 | 0 × 100 | |
| T3 (48 h) | 0 × 100 | 0 × 100 | 0 × 100 | 0 × 100 | |
| E. coli | Control sample | 1.5 × 108 | 1.5 × 108 | 1.5 × 108 | 1.5 × 108 |
| T1 (3 h) | ≈1.5 × 108 | ≈1.5 × 108 | ≈1.5 × 108 | ≈1.5 × 108 | |
| T2 (24 h) | 5 × 10 0 | 1 × 10 0 | 1 × 10 0 | 0 × 100 | |
| T3 (48 h) | 0 × 100 | 0 × 100 | 0 × 100 | 0 × 100 | |
| P. aeruginosa | Control sample | 1.5 × 108 | 1.5 × 108 | 1.5 × 108 | 1.5 × 108 |
| T1 (3 h) | ≈1.5 × 108 | ≈1.5 × 108 | ≈1.5 × 108 | ≈1.5 × 108 | |
| T2 (24 h) | 0 × 100 | 0 × 100 | 0 × 100 | 0 × 100 | |
| T3 (48 h) | 0 × 100 | 0 × 100 | 0 × 100 | 0 × 100 | |
| C. albicans | Control sample | 1.5 × 108 | 1.5 × 108 | 1.5 × 108 | 1.5 × 108 |
| T1 (3 h) | ≈1.5 × 108 | ≈1.5 × 108 | ≈1.5 × 108 | ≈1.5 × 108 | |
| T2 (24 h) | 0 × 100 | 0 × 100 | 0 × 100 | 0 × 100 | |
| T3 (48 h) | 0 × 100 | 0 × 100 | 0 × 100 | 0 × 100 |
Disclaimer/Publisher’s Note: The statements, opinions and data contained in all publications are solely those of the individual author(s) and contributor(s) and not of MDPI and/or the editor(s). MDPI and/or the editor(s) disclaim responsibility for any injury to people or property resulting from any ideas, methods, instructions or products referred to in the content. |
© 2023 by the authors. Licensee MDPI, Basel, Switzerland. This article is an open access article distributed under the terms and conditions of the Creative Commons Attribution (CC BY) license (https://creativecommons.org/licenses/by/4.0/).
Share and Cite
Dobos, A.M.; Popa, A.; Rimbu, C.M.; Filimon, A. Structure-Bioactivity Relationship of the Functionalized Polysulfone with Triethylphosphonium Pendant Groups: Perspective for Biomedical Applications. Polymers 2023, 15, 877. https://doi.org/10.3390/polym15040877
Dobos AM, Popa A, Rimbu CM, Filimon A. Structure-Bioactivity Relationship of the Functionalized Polysulfone with Triethylphosphonium Pendant Groups: Perspective for Biomedical Applications. Polymers. 2023; 15(4):877. https://doi.org/10.3390/polym15040877
Chicago/Turabian StyleDobos, Adina Maria, Adriana Popa, Cristina Mihaela Rimbu, and Anca Filimon. 2023. "Structure-Bioactivity Relationship of the Functionalized Polysulfone with Triethylphosphonium Pendant Groups: Perspective for Biomedical Applications" Polymers 15, no. 4: 877. https://doi.org/10.3390/polym15040877
APA StyleDobos, A. M., Popa, A., Rimbu, C. M., & Filimon, A. (2023). Structure-Bioactivity Relationship of the Functionalized Polysulfone with Triethylphosphonium Pendant Groups: Perspective for Biomedical Applications. Polymers, 15(4), 877. https://doi.org/10.3390/polym15040877






